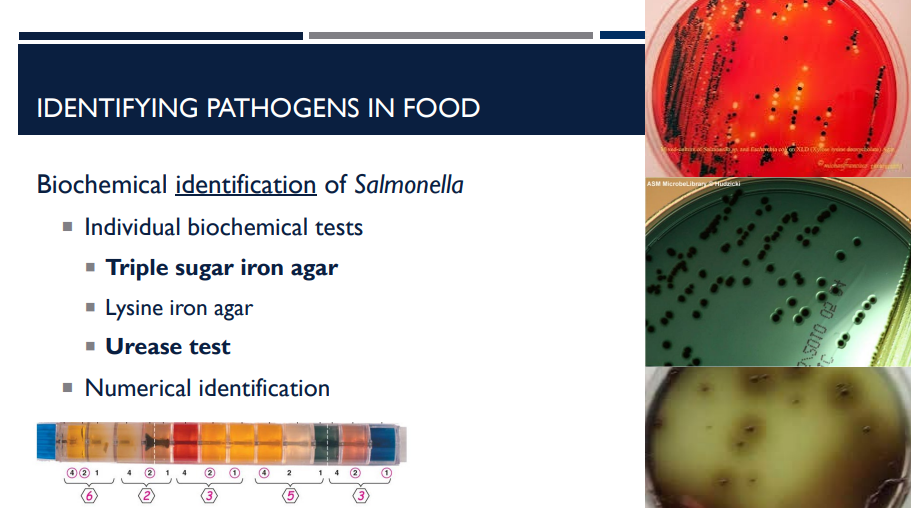
<p>Salmonella has a specific set of metabolic traits that distinguish it from other bacteria. Therefore, biochemical testing can be really useful. What tests are they?</p>

BIOL 251 Exam 4 Food Microbiology
1/50
There's no tags or description
Looks like no tags are added yet.
Name | Mastery | Learn | Test | Matching | Spaced | Call with Kai |
|---|
No study sessions yet.
51 Terms
(LC) The ability of microbes to ferment different compounds is used to produce a variety of foods. Which of the following are possible products of fermentation? Select all that apply.
Lactic acid
Acetic acid
Pyruvic acid
Glucose
Carbon dioxide
Ethanol
NADH
Citric acid
A, B, E, and F
Lactic acid, acetic acid, carbon dioxide, and ethanol are all products of fermentation. Other possible products of fermentation are shown below.

Milk + bacteria + rennin (enzyme) =
cheese

Cheese is made by using microbes + enzymes to transform milk into what and what, then allowing it to ripen?
solid curds and liquid whey

Describe the steps of how microbes interact with cheese.
1. Milk + bacteria + rennin
Milk is the starting ingredient.
Rennin (rennet) is an enzyme that causes milk proteins (casein) to coagulate.
Lactic acid bacteria are added to ferment lactose (milk sugar) into lactic acid, which:
Lowers pH
Helps curd formation
Adds flavor
2. Curd (solid)
After rennin and bacteria act on the milk, it separates into:
Curds → the solid part that becomes cheese
Curds contain:
Casein proteins
Fat
Microbes that continue to modify flavor
3. Whey (liquid)
The leftover liquid after curds form.
Mostly water + lactose + minerals.
Drained off in most cheeses.
4. Ripening (Aging)
Curds are allowed to ripen, sometimes for months or years.
During ripening:
Microbes break down proteins and fats
Unique flavors, textures, and aromas form
Different cheeses use different microbes:

What are the different types of microbes used in cheese?
Lactic acid bacteria, Propionibacterium, and Penicillium (mold).

Yogurt is made by fermenting milk with specific bacteria that transform lactose into lactic acid, giving yogurt its texture, taste, and slightly tangy flavor. The starter cultures that ferment lactose → lactic acid are called Lactic Acid Bacteria. Describe the 2 different types.
Streptococcus thermophilus
Mainly responsible for acid production.
Lactobacillus delbrueckii
Contributes flavor and aroma.

Probiotic yogurts contain additional beneficial bacteria, such as:
Bifidobacterium spp.
Lactobacillus spp. (other strains besides L. delbrueckii)

Unlike many foods, yogurt is not pasteurized after fermentation. This means that there is no ____ step after adding bacteria.
kill

Describe the steps of making wine. (lowkey kinda reminds me of when the people in the 8 show made their own alcohol)
Grapes are harvested and crushed
Sulfites added (antimicrobial)
Yeast is added and wine is fermented
Wine is pressed and filtered
Wine is aged
Wine is bottled

Describe the steps of making beer.
Beer is made by fermenting grains using specific microorganisms to produce alcohol, flavors, and acidity.
Mashing: Grains (usually barley) are soaked in hot water. The mixture of water and grains is called the mash.
Wort – liquid portion of the mash. Contains sugars, proteins, and nutrients for fermentation. This is what gets boiled and flavored before yeast is added.
Hops and other flavors are added
Fermentation using selected microbes. Microbes convert sugars into alcohol, CO2, and flavor compounds. The key microbes are saccharomyces (yeast) → alcohol, Brettanomyces (yeast) → acetic acid, Lactobacillus (bacteria) → lactic acid
Bottling and aging. May be filtered.

What is wort, in context of making beer?
Wort – liquid portion of the mash

The key microbes used for fermentation of select microbes are the following. What does each one produce?
Saccharomyces (yeast)
Brettanomyces (yeast)
Lactobacillus (bacteria)
Saccharomyces (yeast) → alcohol
Brettanomyces (yeast) → acetic acid
Lactobacillus (bacteria) → lactic acid
(LC) You are working for a brewery and are responsible for growing a yeast culture that produces ethanol. The yeasts are growing well on the maltose (sugar) medium but are not producing alcohol. What is the most likely explanation?
The temperature is too high.
The temperature is too low.
The maltose is toxic.
There is oxygen in the medium.
Not enough protein is provided in the medium.
Not enough sugar is provided in the medium.
D
Yeasts are facultative anaerobes. When oxygen is preseent, they will use aerobic respiration, which does not produce alcohol.
The yeast cells will use alcohol fermentation when oxygen is not available. Therefore, oxygen must be removed for alcohol to be produced.

Why is detecting harmful microbes (pathogens) in food tricky? What are the solutions?
Low levels in food (solution: enrichment methods)
Pathogens often exist in very small numbers, far below the total microbial population in food.
May be stressed or injured (Food processing (heat, refrigeration, drying, preservatives) can stress or damage bacteria. Stressed cells may grow slowly & fail to form colonies on standard media (solution: enrichment methods)
Most pathogens do not cause food spoilage.
Harmful bacteria often don’t change the appearance, smell, or taste of food. This is why contaminated food can look, smell, and taste normal.
Key takeaway
Detecting pathogens in food requires special techniques (enrichment, selective media, molecular tests) because they are rare, stressed, and “invisible”.

Detecting pathogens in food requires special techniques (enrichment, selective media, molecular tests) because they are rare, stressed, and “invisible”. Describe primary non-selective pre-enrichment.
Allow all microorganisms to grow

Detecting pathogens in food requires special techniques (enrichment, selective media, molecular tests) because they are rare, stressed, and “invisible”. Describe secondary selective pre-enrichment.
Inhibits the growth of some microorganisms
Encourages growth of target organism(s)

The purpose of Cultural Enrichment is to increase the number of target pathogens to detectable levels (detecting pathogens in food). What are the two types of cultural enrichment?
Non-selective pre-enrichment
Selective secondary enrichments

The purpose of Cultural Isolation is to Detect and presumptively identify the pathogen. (detecting pathogens in food). What kind of agar is used? Why?
Selective/differential agars
Allows for detection of presumptive positive colonies (These are not confirmed yet—further tests are needed.)
Species identification must be confirmed
Salmonella has a specific set of metabolic traits that distinguish it from other bacteria. Therefore, biochemical testing can be really useful. What tests are they?
Individual biochemical tests
Triple sugar iron agar
Lysine iron agar
Urease test
Numerical identification

Serotyping is a method of identifying pathogens in food. Explain what it does.
Serotyping is a method used to classify bacteria based on their surface antigens.
Identification of O & H antigens
Useful for tracking outbreaks

What are the overall problems of detecting pathogens in food and their solutions?
Low levels (enrichment methods)
May be stressed or injured (enrichment methods)
Testing can take several days (development of rapid methods)
Testing is destructive (test multiple samples)
Not evenly dispersed (test multiple representative samples)

Sometimes testing directly for pathogens is difficult or expensive. Instead, we use index or indicator organisms to assess food safety. Describe index organisms.
Definition: Organisms whose presence suggests that pathogens may also be present.
Organisms similar to pathogens, but easier to test for

Sometimes testing directly for pathogens is difficult or expensive. Instead, we use index or indicator organisms to assess food safety. Describe indicator organisms.
Definition: Organisms used to indicate a failure in a process (e.g., sanitation, pasteurization, sterilization).
Survives at least as well as pathogenic organisms
Was the treatment sufficient to eliminate potential pathogens?

Microbial testing ensures milk is safe for consumption and properly processed. What are the microbial requirements for pre-pasteurized milk (raw milk)?
Aerobic plate count < 100,000 CFU/ml (index)
More microbes = higher chance of one or more pathogens

Microbial testing ensures milk is safe for consumption and properly processed. What are the microbial requirements for pasteurized milk?
Aerobic plate count < 20,000 CFU/ml (indicator)
Coliform count < 10 CFU/ml (index)
Did the process reduce microbial counts to a safe level?

Explain what serial dilution and plating does.
This method is used to estimate the number of viable bacteria in a food sample.

Explain the process of serial dilution & plating.
1. Serial Dilution
The original sample is diluted in a stepwise manner using 10-fold dilutions.
Example: 1 mL of sample + 9 mL diluent = 10⁻¹ dilution
Take 1 mL from that tube + 9 mL new diluent = 10⁻², and so on.
Each dilution reduces the bacterial concentration by 90% (10-fold decrease).
Purpose: To get a dilution where the number of colonies is countable (usually 30–300 colonies per plate).
2. Plate Each Dilution (1 mL or 100 μL)
After preparing 10-fold serial dilutions, a measured volume of each dilution is plated:
1 mL (common for pour plates)
100 μL (0.1 mL) (common for spread plates)
Plating multiple dilutions increases your chance of getting a plate with a countable number of colonies.
3. Nonselective Media (APC)
APC = Aerobic Plate Count
Uses nonselective agar (like Plate Count Agar) to let all viable aerobic microbes grow.
Gives an estimate of the total number of organisms present in the sample.
4. Selective/Differential Media
Used to count specific organisms or groups.
These plates help detect particular contaminants of interest.
4. Countable Range: 25–250 Colonies
Only plates containing 25 to 250 colonies are used for accurate calculations.
<25: too few to be statistically reliable
250: too crowded; colonies may overlap or be missed

What is the equation for CFU/ml?
Number of colonies / Dilution factor x Volume

idk


(LC) You performed a serial dilution from a milk sample as shown and observed the following results. Calculate the CFU/ml of your sample.
33000
33 colonies
1 ml
10-3 dilution
CFU/ml = # colonies/(dilution factor x volume)
CFU/ml = 33 colonies/(10-3 x 1 ml) =
33,000 CFU/ml
What are index and indicator organisms?
Index organism: Microbes that suggest a pathogen might be present.
Indicator organism: Microbes that show whether a food safety process worked properly (pasteurization, sanitation, heat treatment, etc.).

What are the problems associated with detecting index and indicator organisms in food?
May be stressed or injured (enrichment methods)
Not evenly dispersed (test multiple samples)
Testing can take several days (development of rapid methods)
Low levels of index and indicator organisms does not mean that there are no pathogens in the food!

T/F: Low levels of index and indicator organisms does not mean that there are no pathogens in the food.
T

T/F: Low levels of index and indicator organisms mean that there are no pathogens in the food.
F. Low levels of index and indicator organisms does not mean that there are no pathogens in the food.

Describe pasteurization. (food processing to reduce microbial load)
High-temperature, short time (HST)
72 degrees C for 15 seconds
Kills most, but not all microbes

Describe ultra high temperature (UHT) treatment. (food processing to reduce microbial load)
Ultra-high temperature (UHT) treatment
140 C for 4 seconds
Kills all microbes

Describe the process of canning (food processing to reduce microbial load)
Heat (steam under pressure)
Removal of oxygen
12D treatment = 12 log reduction of Clostridium botulinum endospores (1,000,000,000,000 endospores reduced to 1 endospore)
(LC) Match each of the following types of organisms to the correct range of growth temperatures.
Mesophiles -
Thermophiles -
Hyperthermophiles -
Psychrotrophs -
Mesophiles - 10 – 50º C
Thermophiles - 40 – 72º C
Hyperthermophiles - 65 – 110º C
Psychrotrophs - 0 – 30º C


Canned foods can still get spoiled. Describe Thermophilic anaerobic spoilage and the species it is associated with.
Thermophilic bacteria survive canning process (endospores)
Improper storage allows thermophilic bacteria to grow at high temperatures
Bacteria produce gas, causing can to swell
pH decreases; sour odor
Clostridium species

Canned foods can still get spoiled. Describe flat, sour spoilage and the bacteria it is associated with.
Inadequate processing allows for survival of thermophilic organisms (endospores)
Improper storage allows bacteria to grow at high temperatures
No gas production
Geobacillus stearothermophilis
Industry standards limit number of thermophilic organisms allowed in raw materials

Canned foods can still get spoiled. Describe mesophilic spoilage and the bacteria it is associated with.
Occurs at normal storage temperatures
Produces strong odors
Food is underprocessed
Endospore-forming bacteria
Clostridium botulinum
Leakage during cooling
Non-endospore-forming bacteria

Describe how food is packaged to reduce microbial load, and the treatments used for aseptic packaging.
Food and packaging are treated separately
Food is put into packaging in a sterile environment
Treatment for aseptic packaging
Heat
Hydrogen peroxide
UV radiation
High energy electron beams

Describe how radiation helps to reduce microbial load in food processing.
Radiation
X-rays
Gamma rays
Low doses to kill insects
Pasteurizing doses to kill pathogens on meat and poultry
High doses to sterilize spices
Spices normally have 1,000,000+ CFU/g! (usually not hazardous)

Describe how high pressure helps to reduce microbial load in food processing.
Prewrapped fruits
Deli meats
Precooked meat products
87,000 psi of pressure kills many common foodborne pathogens and spoilage bacteria
Preserves taste and color better than other methods

What is the best method in reducing microbial load for food processing if your priority was to preserve taste and color?
High pressure

Open dating is used to provide consumers with the estimated period of time when the food will be the best quality and to help the store determine how long to display the food. Describe “Best if used by/before"
“Best if used by/before” – indicates when a product will be of best flavor or quality

Open dating is used to provide consumers with the estimated period of time when the food will be the best quality and to help the store determine how long to display the food. Describe “Sell by”
“Sell by” – tells the store how long to display the product for inventory management

Open dating is used to provide consumers with the estimated period of time when the food will be the best quality and to help the store determine how long to display the food. Describe “Use by”
“Use by” – last recommended date for use of product while at peak quality

Open dating is used to provide consumers with the estimated period of time when the food will be the best quality and to help the store determine how long to display the food. Describe “freeze by”
“Freeze by” – last date to freeze a product for peak quality

T/F: Labels like “freeze by, sell by, use by, best if used by,” are safety dates for the consumer.
F, they are NOT safety dates.
What are the 4 steps to have food safety at home?
Clean
Seperate
Cook
Chill